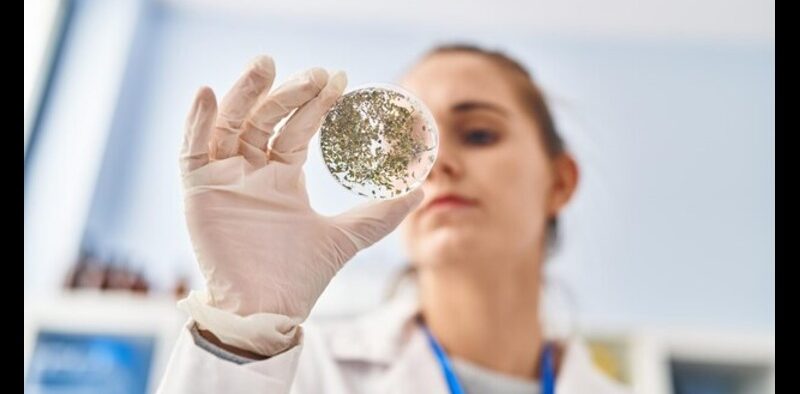

Hydrogel Revolutionizes Localized Cancer Treatment
Share
Scientists at the Indian Institute of Technology, Guwahati, and Bose Institute Kolkata have developed a novel injectable hydrogel with advanced properties to treat localized cancers. This groundbreaking approach to hydrogel-based therapy enables the direct delivery of anti-cancer drugs at the tumor site, thus significantly reducing the harm caused by the side effects associated with chemotherapy and surgery.
Cancer is one of the most daunting global health challenges with millions affected yearly. Although a lot has been discovered in medical science, the present modes of treatment are plagued with various shortcomings. Surgery to remove the tumors is often impossible due to the situation being interna -organ-based, whereas chemotherapy, the backbone of cancer treatment, suffers from systemic toxicity. Chemotherapeutic agents, when administered throughout the body, affect both cancerous and healthy cells, causing severe side effects and compromising the quality of life of the patient. Recognizing these challenges, researchers have been striving to develop targeted therapies that can improve efficacy while sparing healthy tissues.
This multi-institutional research, led by Professor Debpratim Das from IIT Guwahati’s Department of Chemistry, marks a significant stride toward that goal. The hydrogel developed by the team is designed to deliver anti-cancer drugs precisely to the tumor microenvironment, ensuring localized action while minimizing systemic exposure. The result is a treatment method that is both effective and less toxic.
Speaking on the innovation, Professor Das mentioned, “This work shows exactly how scientific innovation can be targeted directly to meet the most critical needs in cancer treatment. This hydrogel, its unique properties are what let it be at home in the biological environment and, in turn, bring precision where precision is most needed. We are excited by the prospect of changing our way of thinking about localized drug delivery.
Hydrogels are three-dimensional polymer networks, water-based, and capable of absorbing and retaining fluids. Because of their structural similarity to living tissues, they are particularly suited for biomedical applications. The newly synthesized hydrogel is based on ultra-short peptides that are biocompatible and biodegradable building blocks of proteins. This makes the hydrogel safe for biological use, and its design ensures that it will remain localized at the injection site without dissolving in biological fluids.
What makes this hydrogel so special is that it responds to increased glutathione (GSH) concentration-a molecule with a high content within tumor cells. When this hydrogel is exposed to elevated GSH, it initiates the controlled release of the anti-cancerous drug, targeting it directly at the tumor. This specificity lowers the interaction between the drug and healthy tissues; therefore, there is a possibility of systemic side effects.
The hydrogel is showing promising preclinical trials using a murine model of breast cancer. Single injection of this hydrogel with the chemotherapy drug Doxorubicin resulted in a reduction of almost 75% in the tumor size within as short a duration as 18 days. A notable feature here is that it remained localized to the tumor site, releasing the drug steadily with time without inflicting any kind of detectable damage to the other organs.
In addition to its targeted drug delivery, the hydrogel also enhances the therapeutic efficacy of the drug. Laboratory studies showed that it increases the uptake of the drug by cancer cells, causes cell cycle arrest, and induces programmed cell death, all of which attack the tumor from different angles. These properties not only maximize the impact of the drug on cancer cells but also allow for reduced dosages, further minimizing toxicity and improving patient outcomes.
Researchers are hopeful about the wider applications of this innovation. Although preliminary experiments have shown that the hydrogel can significantly reduce the size of a tumor of breast cancer, continuing studies are being conducted in other types of tumors. The group also is looking into the extent of tumor size reduction possible with a single dose. Following this, the team will submit to clinical trials with the aim of seeking industry partnership to take it to the world of cancer treatments.
This hydrogel development is a crucial step in the fight against cancer. The ability to offer a localized, precise, and minimally toxic treatment option has the potential to greatly improve patient outcomes and redefine the standards of cancer therapy. With further research and clinical validation, this innovative hydrogel could soon become a cornerstone of modern oncology.



















